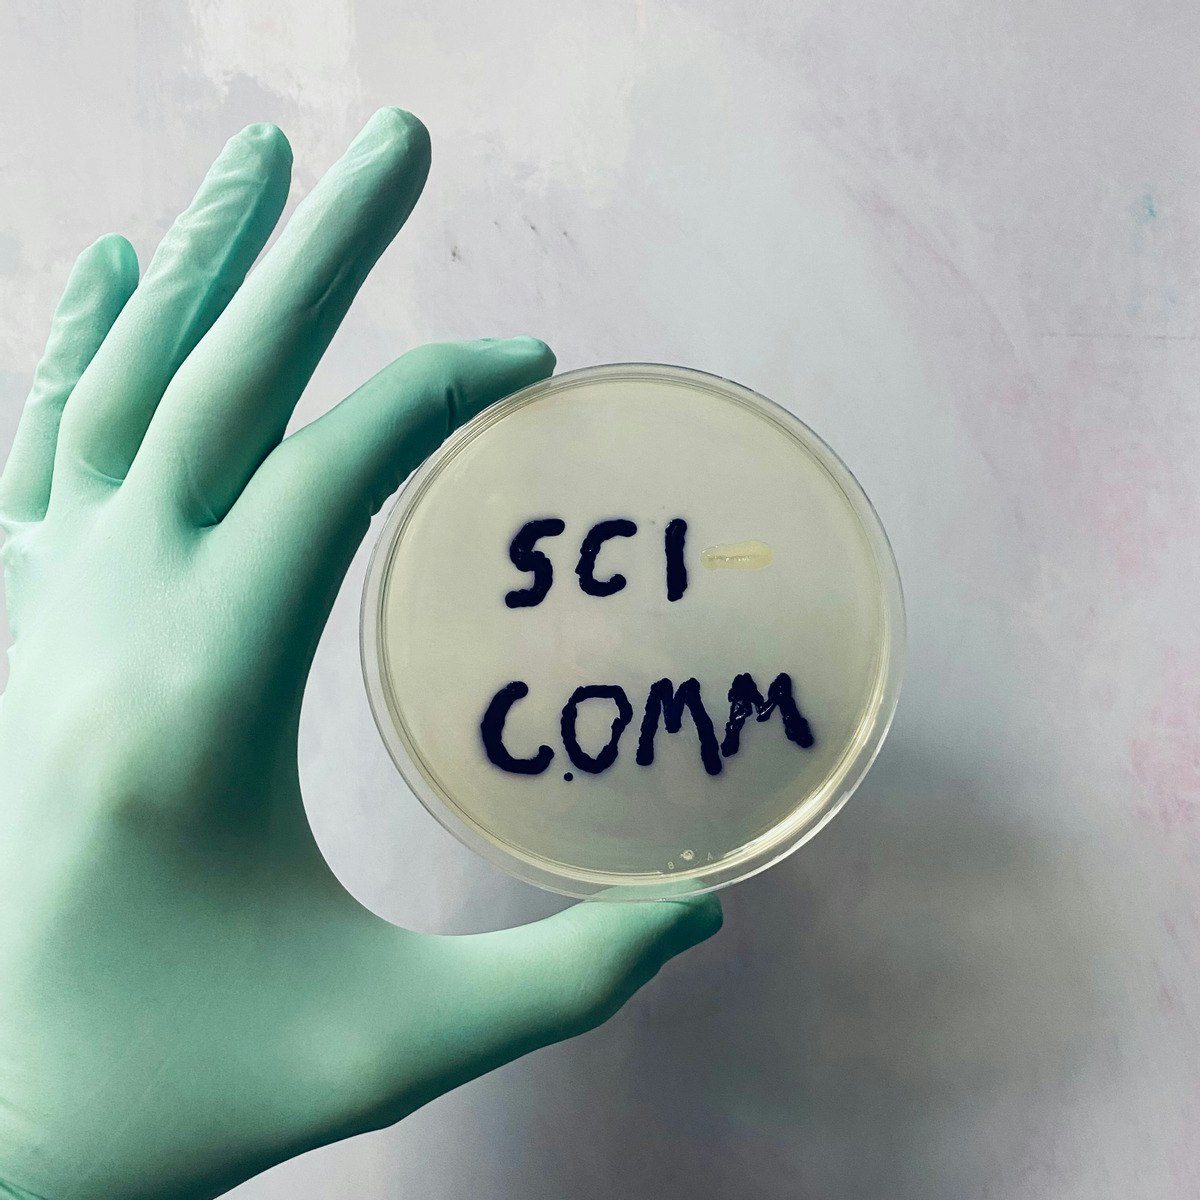

材料科学课程可以帮助您了解材料特性、材料选择、纳米技术和热力学原理。您可以掌握分析材料行为、进行实验和应用统计方法解释数据的技能。许多课程介绍了扫描电子显微镜、X 射线衍射和材料特性建模软件等工具,支持航空航天、电子和生物医学工程等行业的实际应用。

University of Colorado Boulder
您将获得的技能: 运动医学, 免疫学, 慢性疾病, 呼吸, 心理健康, 生理学, 公共卫生, 运动科学, 营养与饮食, 生物化学, 运动训练, 内分泌学, 预防保健, 药理学, 公共卫生与疾病预防, 运动学, 生命体征
初级 · 课程 · 1-4 周

Yale University
您将获得的技能: 弹性, 正念, 压力管理, 设定目标, 行为健康, 决策, 自我意识, 心理学, 积极性, 心理健康, 成长意识
初级 · 课程 · 1-3 个月

University of Michigan
您将获得的技能: Environmental Monitoring, Global Positioning Systems, Environmental Science, Physics, Mechanical Engineering, Environment, Physical Science, Climate Change Programs, Engineering Calculations, Geographic Information Systems, Scientific Methods, Manufacturing and Production, World History, Chemical Engineering, International Relations, Engineering Analysis, Electrical Power, Political Sciences, Emerging Technologies, Timelines
初级 · 专项课程 · 1-3 个月

Imperial College London
您将获得的技能: Python 程序设计, 数据操作, 机器学习算法, 人工神经网络, 衍生产品, 微积分, 机器学习, 回归分析, 应用数学, Algorithm, NumPy, 概率与统计, 数据科学, Machine Learning 方法, 统计分析, Jupyter, 高等数学, 统计, 降维, 线性代数
初级 · 专项课程 · 3-6 个月
University of Colorado Boulder
您将获得的技能: 写作, 叙事, 媒体与传播, 技术写作, 科学与研究, 口头表达, 摄影, 科学方法, 计划评估, 人类学习, 技术交流, 教育与培训, 面试技巧, 教育软件和技术, 社区外联, 研究, 信息图表, 说服沟通, 学习理论, 教学法
初级 · 课程 · 1-3 个月

Technical University of Denmark (DTU)
您将获得的技能: 可持续发展, 水资源管理, 适应气候变化, 文化敏感性, 水质, 环境工程, 尽量减少废物, 土木工程, 环境政策, 雨水管理, 环境与资源管理, 水资源的可持续性, 可持续技术
中级 · 课程 · 1-3 个月

Stanford University
您将获得的技能: 文化多样性, 膳食计划和准备, 健康促进, 慢性疾病, 健康信息学, 营养与饮食, 公共卫生, 健康教育, 烹饪, 行为管理
初级 · 课程 · 1-3 个月

University of Colorado System
您将获得的技能: 预测建模, Google 云端平台, 数据操作, 自然语言处理, 数据建模, 遵守《健康保险便携性和责任法案》(HIPAA), 临床信息学, 生物信息学, 医疗隐私, 文本挖掘, 数据伦理, 信息学, 重症监护室, R 语言程序设计(中文版), 临床数据管理, 数据库设计, 风险模型, 摘录, Tidyverse(R 软件包), 数据质量
中级 · 专项课程 · 3-6 个月

University of California, Davis
您将获得的技能: 数据叙事, 数据分析, Data Governance, 数据建模, JSON, 描述性统计, 探索性数据分析, 演讲, 数据库, SQL, Apache Spark, 统计分析, 同行评审, 分布式计算, 解决复杂问题, 数据可视化, 数据管道, 数据湖, 数据库设计, 数据质量
初级 · 专项课程 · 3-6 个月

您将获得的技能: Python 程序设计, 数据可视化软件, 描述性统计, 数据分析, 数据导入/导出, Pandas(Python 软件包), 存储过程, SQL, 网页抓取, 关系数据库, 数据科学, 概率分布, 编程原则, 统计分析, 统计, 仪表板, 数据可视化, Jupyter, 数据展示, 计算机编程工具
攻读学位
初级 · 专项课程 · 3-6 个月

Johns Hopkins University
您将获得的技能: 统计编程, 数据分析, 数据结构, 数据导入/导出, 调试, 模拟, 编程原则, R 语言程序设计(中文版), 统计分析, 性能调整, 计划发展, 计算机编程工具
中级 · 课程 · 1-4 周

Deep Teaching Solutions
您将获得的技能: 创造力, 学习策略, 时间管理, 生产率, 压力管理, 精神集中, 自律, 适应, 认知灵活性, 愿意学习, 成长意识
初级 · 课程 · 1-4 周